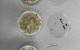

이날 박 후보는 “민주당 결선에서 성원을 보내주신 담양군민과 당원 여러분께 머리 숙여 깊이 감사드린다”며 “오늘의 결과는 박종원의 승리가 아니라 멈춰선 담양의 시계를 다시 돌리고 새로운 미래를 열망하는 군민 모두의 승리”라고 밝혀 ‘준비된 군수’, ‘검증된 군수’로서의 저력을 입증했다.
■ 4대 비전: 미래 성장 설계, 지역 경제 회복, 공직 사회 안정, 담양 가치 복원
박 후보는 담양의 새로운 미래를 위한 4대 비전을 제시했다.
■ ‘담양예산 1조 시대’… ‘봉산역과 고서역’ AI스마트 농업과 반도체 밸리
경제 분야에서는 담양의 지리적 이점과 첨단 기술을 결합한 ‘미래 먹거리’ 확보, 농업의 AI스마트 농업으로의 전환에 방점을 찍었다.
박 후보는 “산업 혁신을 위해 현재 봉산면 제2일반산단이 미래차 소부장으로 계획돼 있으나, 이를 일부 수정해 고품격 주거단지와 비즈니스센터, 대형복합쇼핑시설 등으로 전환하고 ‘AI 스마트 농산업 실증도시’를 조성해 농업 분야의 AI 전환을 선도하겠다”고 밝혔다.
이어 “담양광주 20분 생활권으로 광주의 대학병원과 주요시설을 담양권으로 흡수하겠다”며 “담양역 경전철 개설과 시내버스 노선조정으로 인구유입 동력을 확보하고 광주 북구청장과 장성군수, 담양군수 그리고 특별시장 4자 협의체를 구성해 ‘담양 예산 1조 원 시대’ 조기 달성하겠다”는 포부 또한 놓치지 않았다.
■ 전국 삶의 질 1위… ‘함께 잘 사는 진짜 담양’
이어 박 후보는 “담양의 정신과 문화 자산이 군민의 일상 속 삶의 질로 이어지게 하겠다”며 “개발제한구역을 이용한 정원문화로 담양 12개 읍면을 잇고 이를 군민 소득으로 이어질 수 있게 전략적으로 접근하겠다”고 말했다.
그는 “어르신들을 위한 촘촘한 통합돌봄 복지 체계를 강화하고 단 한 사람의 군민도 소외되지 않는 ‘전남 삶의 질 1위, 전국 삶의 질 8위’를 ‘전국 삶의 질 1위’로 올리기 위해 노력하겠다”고 강조하며 “대단위 주거단지 개발 사업이 실현되면 군사시설 이전 문제는 자연스럽게 해결될 수 있다”고 밝혔다.
■ 1호 결재는 ‘민생경제 긴급계획’
박 후보는 취임 직후 ‘민생경제 긴급계획’을 1호 결재로 삼아, 고물가로 인한 경기 침체로 어려워진 군민의 삶을 우선 돌보겠다고 공언했다.
그는 “4자 협의체로 중앙정부와의 긴밀한 협조를 펼칠 것이며 정부여당 민주당 군수 후보로서 취임 직후 100일 과제 또한 철저히 준비해 군민들께 ‘민주당 후보로서의 승리’는 물론 ‘민생경제 회복’으로 진정성 있게 보답하겠다”고 말했다.
마지막으로 박 후보는 “인구절벽시대를 극복하기 위해 전남과 광주가 다시 통합한 절체절명의 뜻을 잊지 않고 예산을 어떻게 소비하느냐에 매몰되기보다 소중한 예산을 담양 미래를 위해 알뜰히 투자하겠다”는 뜻을 밝히며 “끝까지 최선을 다해 이재명 정부의 기본소득사회 또한 반드시 실현하겠다”고 민주당 후보 확정 소감을 밝혔다.


 2026.04.16 (목) 17:54
2026.04.16 (목) 17:54